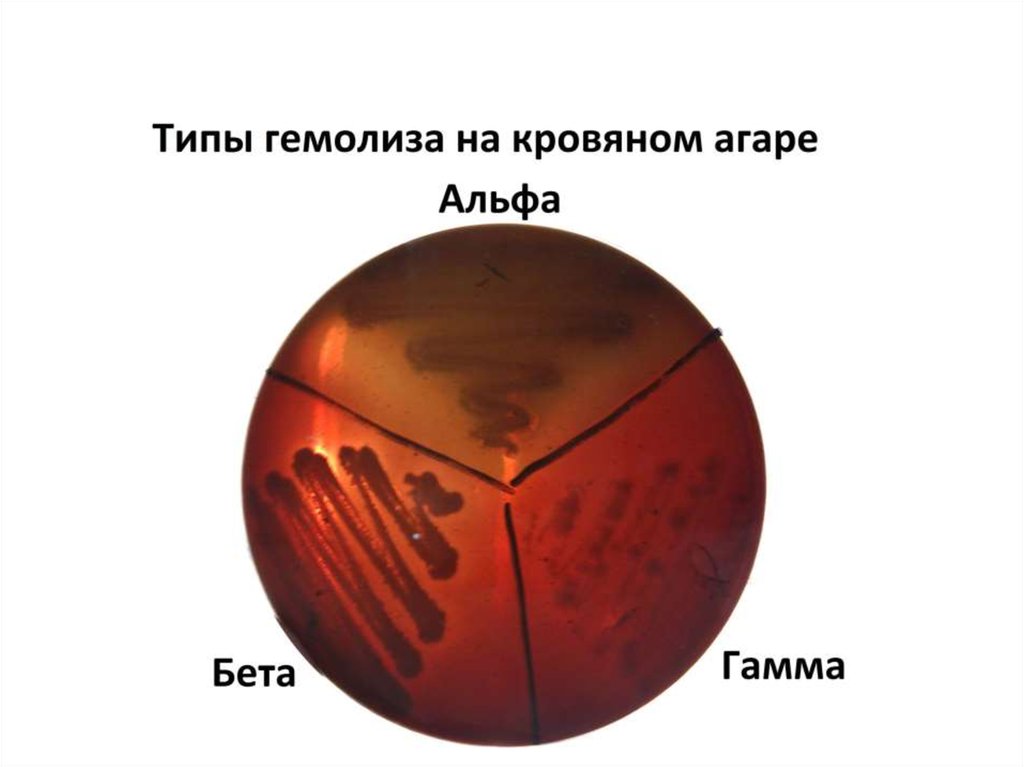
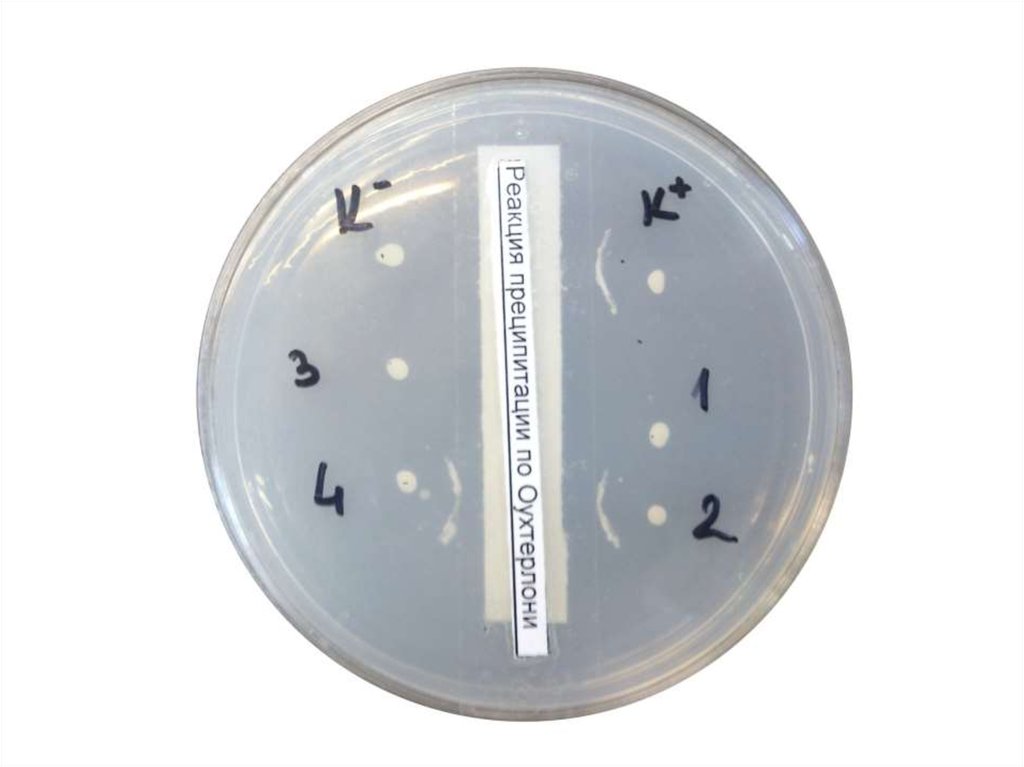
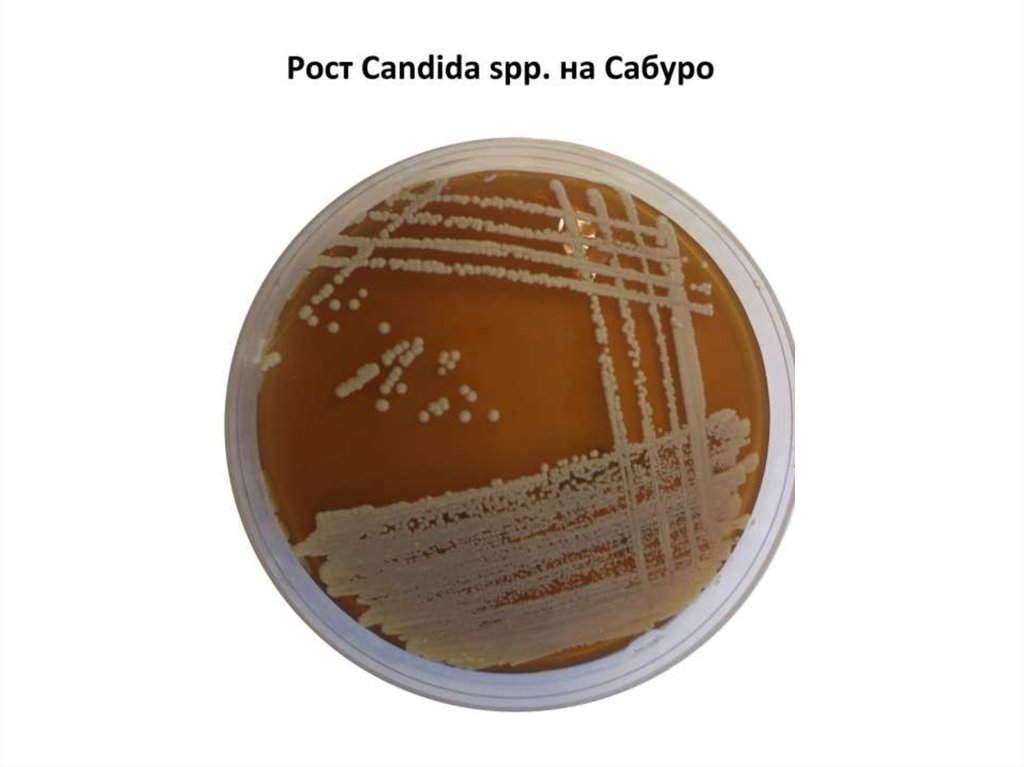
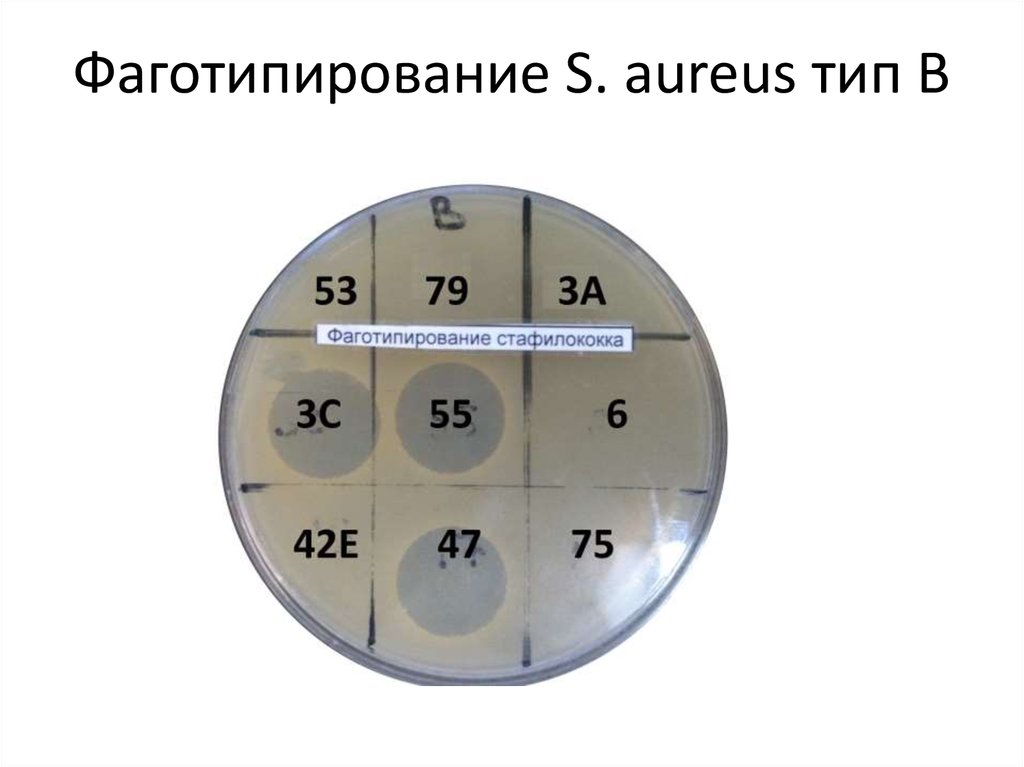
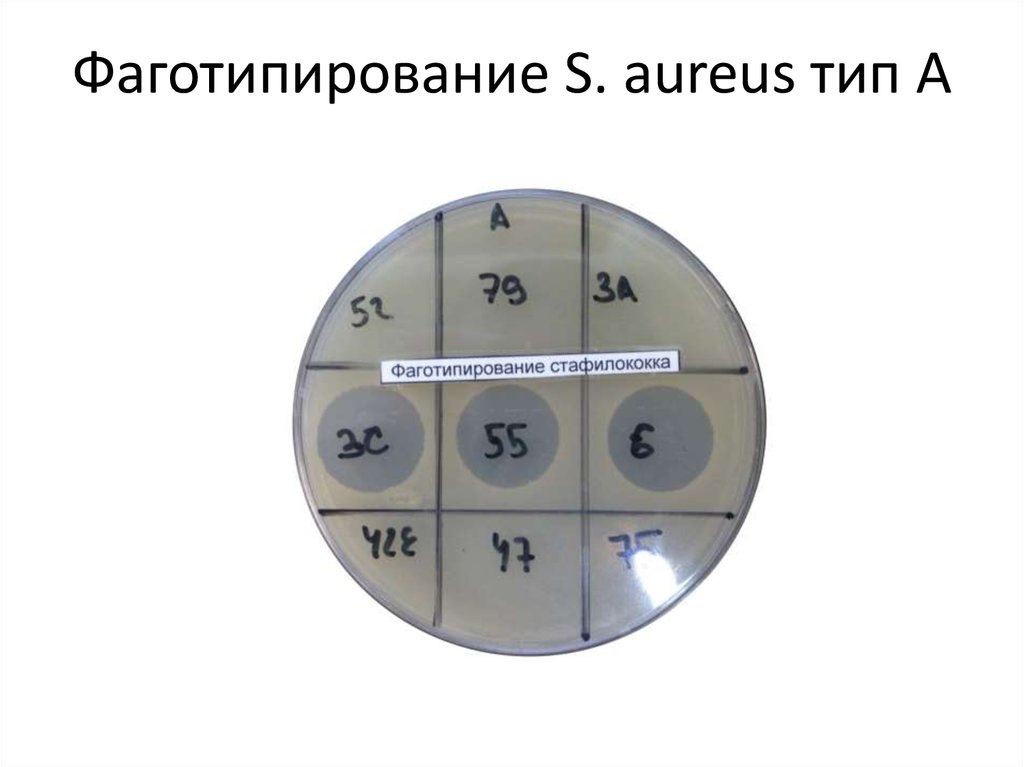
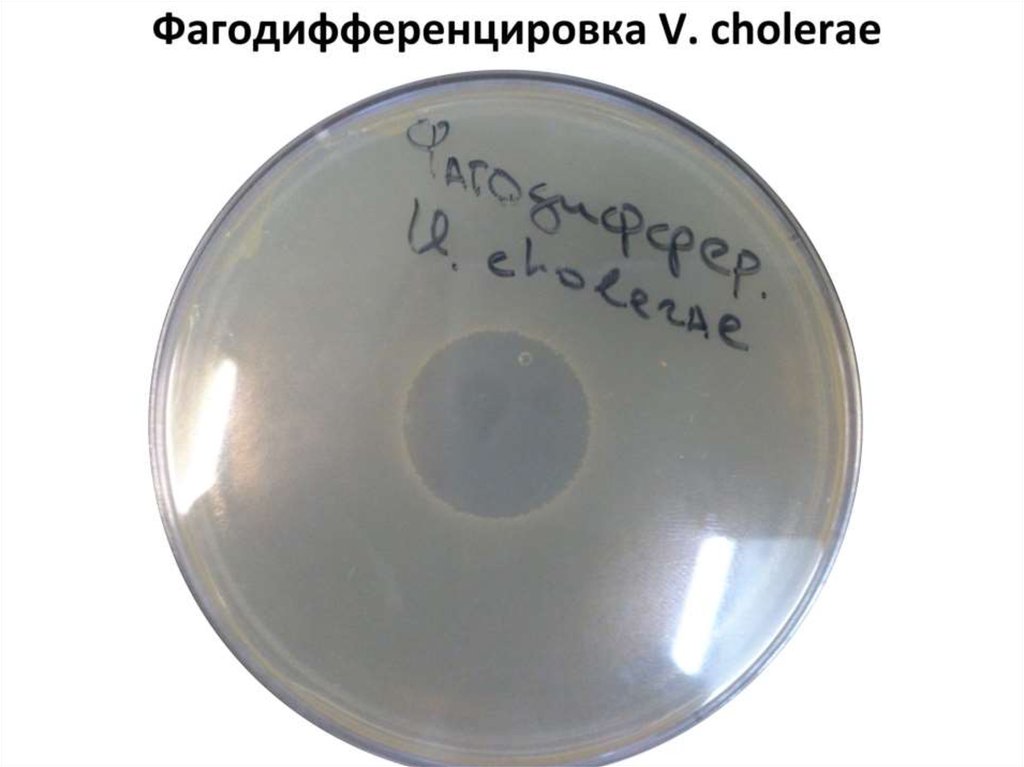
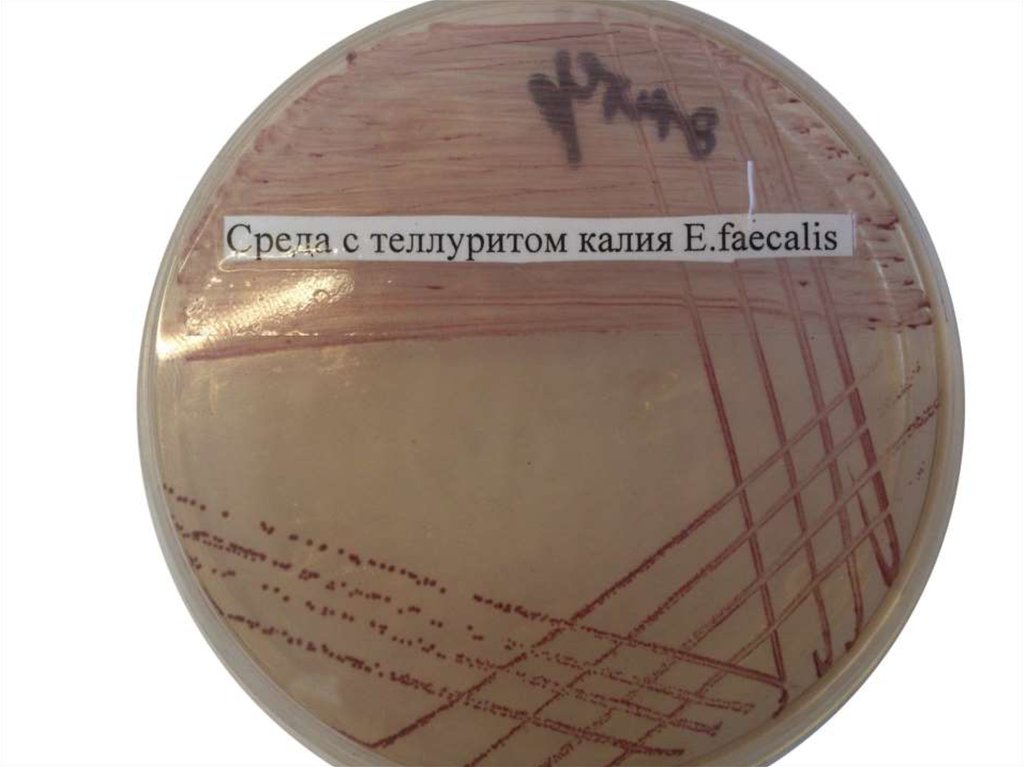

Похожие презентации:
Серодиагностика брюшного тифа
1.
Практические навыки2.
3.
4.
5.
Серодиагностика брюшного тифа(3 варианта)
Применение: диагностика брюшного тифа
Ищем: антитела к отдельным антигенам
Возможности: выявление стадийности заболевания
(Динамика содержания антител к S. typhi своеобразна:
раньше всего появляются антитела к О-антигену, но титр
их быстро снижается после выздоровления; Н-антитела
появляются позднее, но зато сохраняются после болезни и
прививок годами) A-B-C=начало-разгар-исход
В виде РНГА реакция не ставится, только в виде
пробирочной реакции агглютинации Видаля
6.
7.
РНГА с Vi-антигеннымдиагностикумом
Применение: диагностика брюшного тифа и
скрининг брюшнотифозных носителей
Ищем: антитела к Vi-антигену
Возможности: выявление титра антител
более 1/40 означает или носительство, или
наличие заболевания. Больной или
носитель отправляются на
бактериологическое исследование
фекалий, желчи и дуоденального
8.
9.
Серодиагностика дизентерии вРНГА
Применение: диагностика дизентерии
острой, хронической и носительства.
Ищем: антитела к групповым антигенам
шигелл
Возможности: титр антител к
определенному виду 1/200 – 1/400
означает носительство, 1/400 и выше –
острая форма
Примечания: диагностикумов с антигенами
10.
11.
Серодиагностика иерсиниоза ипсевдотуберкулеза в РНГА
Применение: диагностика иерсиниоза и
псевдотуберкулеза.
Ищем: антитела к групповым антигенам
иерсиний
Возможности: титр антител к
определенному виду 1/200 – 1/400
означает носительство, 1/400 и выше –
острая форма
Примечания: ТОЛЬКО в больших панелях, в
12.
13.
Серодиагностика туберкулеза вРНГА
Применение: диагностика туберкулеза.
Ищем: антитела антигенам микобактерий
Возможности: титр антител 1/200 – 1/400
означает хроническую форму, 1/400 и выше
– острая форма
14.
Все методы серодиагностики вРНГА
Диагностикум: эритроцитарный сенсибилизированный
определенным видом антигена (указан где-либо на фото
или планшетке)
Положительный феномен – зонтик
Отрицательный феномен – пуговка
Как правило в микропланшетах диагностическим титром
при ОДНОКРАТНОМ исследовании является титр 1/320, в
макропланшетах – 1/400 и выше (острые заболевания)
Исследование парных сывороток предполагает
нарастание титра антител в 4 раза и более за 12-14 дней
15.
16.
Висмут-сульфит агарТип среды: элективно-дифференциальная
Основа: МПА
Элективный фактор: соли висмута
Дифференциальный фактор: соли висмута и
сульфит натрия (бактерии, образующие
сероводород, восстанавливают S4+ до S2-,
что приводит к почернению среды). Прочие
или остаются зелеными, или не растут.
17.
18.
Типы гемолиза бактерийβ Гемолиз: полное просветление среды
вокруг колоний (среда становится
прозрачной). Характерно для S. aureus, Str.
Pyogenes, некоторых Enterobacteriaceae
α гемолиз: окрашивание среды в
зеленоватый цвет вокруг колоний
(неполное разрушение гемоглобина)
γ гемолиз: нет изменения цвета и
прозрачности
19.
20.
Среда КлаубергаТип среды: элективно-дифференциальная
Основа: МПА с добавлением
гемолизированной крови, глицерина и (по
возможности) витаминов В6 и В12
Элективный фактор: теллурит калия 2%
Дифференциальный фактор: теллурит
калия восстанавливается коринебактерями,
прокрашивая их в черный цвет с
металлическим отливом
21.
22.
Биохимические свойстванейссерий
Тип среды: дифференциальная (комплекс
сред с моно- и дисахаридами)
Основа: МПБ с добавлением моно/дисахарида и индикатор рН
Дифференциальный фактор: в процессе
ферментации моно-/дисахарида рН
меняется в кислую сторону, что меняет цвет
индикатора (в данном случае на красный)
Применение: дифференцировка нейссерий
23.
24.
Реакция преципитации поОухтерлони
Тип реакции: реакция преципитации
Применение: Выявление антигенов
менингококков в ликворе (экспресс-метод)
Ищем: антигены менингококков
Диагностикум: сыворотка поливалентная к
антигенам N. meningitidis
Возможности: выявление реакции Аг+Ат
происходит по формированию полосы
25.
26.
Реакция преципитации поОухтерлони
Тип реакции: реакция преципитации
Применение: Выявление токсина
коринебактерий
Ищем: токсин коринебактерий
Диагностикум: сыворотка к токсину
коринебактерий
Возможности: выявление реакции Аг+Ат
происходит по формированию полосы
27.
28.
Среда Левенстайна-ИенсенаТип среды: элективная
Основа: МПА с добавлением яичного
желтка
Элективный фактор: требуется
предварительная обработка материала от
больного 2% соляной или серной кислотой,
для ингибирования роста плесневых грибов
добавляется бриллиантовый зеленый
Применение: бактериологическое
29.
30.
Проба ПизуТип среды: дифференциальная
Основа: МПА с добавлением цистеина
Дифференциальный фактор: потенциально
токсигенные коринебактерии способны
разлагать цистеин с образованием
сероводорода, который с ионами железа
образует комплекс черного цвета
Применение: оценка токсигенности
коринебактерий
31.
32.
Среда СабуроТип среды: элективная
Основа: МПА с 2 мг/л глюкозы и 10 мкг/мл
гентамицина и /или левомицетина
Элективный фактор: низкий рН и
антибиотики
Применение: бактериологическое
выделение дрожжеподобных грибов рода
Candida и др. грибов
33.
Фаготипирование S. aureus тип В34.
Фаготипирование S. aureus тип А35.
Фаготипирование S. aureusТип реакции: фаготипирование
Исследуемый материал: чистая культура S.
aureus
Инструмент типирования: английский
набор типовых фагов
Положительный феномен: отсутствие роста
в месте аппликации стандартного фага
Цель исследования: определение фаготипа
36.
37.
ТСАТип среды: дифференциальная
Основа: МПА с добавлением 1 мкг/л
глюкозы, 10 мкг/л сахарозы или лактозы,
железа (III) хлорного, цистеина, иногда –
мочевины (ср. Олькеницкого) индикатора
Андраде
Дифференциальный фактор: сахара,
цистеин, мочевина
Применение: дифференцировка
38.
39.
Фагодифференцировка V.cholerae
Тип реакции: фаготипирование
Исследуемый материал: чистая культура V.
cholerae
Инструмент типирования: стандартный
набор фагов
Положительный феномен: отсутствие роста
в месте аппликации стандартного фага
Цель исследования: определение фаготипа
40.
41.
Фагодифференцировка V.cholerae
Тип реакции: фаготипирование
Исследуемый материал: чистая культура V.
cholerae
Инструмент типирования: стандартный
набор фагов, смесь фагов поливалентная
Положительный феномен: отсутствие роста
в месте аппликации стандартного фага
Цель исследования: дифференцировка V.
42.
43.
ЭнтерококкагарТип среды: элективно-дифференциальная,
хромогенная
Основа: МПА с добавлением хромогенного
субстрата и селективной смеси солей
Элективный фактор: смесь солей (скрыто
производителем)
Дифференциальный фактор: 2,3,5трифенилтетразолия хлорид
44.
СРЕДА КОНТРОЛЯ СТЕРИЛЬНОСТИ (Тиогликолевая)Тип среды
Среда для анаэробов (обогатительная)
Состав
Питательная основа - питательный бульон
(мясо-пептонный бульон) + 0,1% агар-агара
Дыхательный субстрат - глюкоза
Редуцирующий фактор - тиоловые соединения
(тиогликолят натрия и цистеин)
Принцип действия
Глюкоза является дыхательным субстратом и
используется в энергетических анаэробных
процессах.
Тиоловые соединения связывают токсичные
формы кислорода и снижают окислительновосстановительный потенциал среды.
Небольшое количество агар-агара повышает
вязкость среды и уменьшает насыщение среды
кислородом в результате конвекции.
Назначение
Накопление анаэробных микроорганизмов.
45.
46.
47.
Желточно-солевой агарТип среды
Элективно-дифференциальная
Состав
Питательная основа - питательный агар (мясо-пептонный агар)
Дифференцирующий фактор - лецитин (эмульсия куринного желтка)
Элективный фактор - 10% хлорида натрия
Индикатор - отсутствует
Принцип действия
Высокая концентрация хлорида натрия подавляет рост
большинства микроорганизмов. Стафилококки при концентрации
соли 10% не подавляются.
Наличие в среде лецитина позволяет дифференцировать
стафилококки по наличию лецитовителазы. При расщеплении
лецитина образуются нерастворимые продукты, выпадающие в
толще среды вокруг колоний, образуя "перламутровую" зону.
Назначение
Выделение стафилококков и дифференцировка по
лецитовителазному признаку (S.aureus - lec+, остальные - lec-) с
одновременным подавлением сопутствующей микрофлоры.
48.
49.
Тип средыЭлективно-дифференциальная
Состав
Питательная основа - питательный агар (мясо-пептонный агар)
Дифференцирующий фактор - лактоза
Элективный фактор - соли желчных кислот
Индикатор - нейтральный красный
Принцип действия
Соли желчных кислот подавляют рост сопутствующей
микрофлоры. Поскольку полного подавления не происходит,
колонии вырастающих микроорганизмов можно
дифференцировать по способности расщеплять лактозу. В
питательной среде накапливаются кислые метаболиты. В
кислой среде нейтральный красный окрашивает
лактозоположительные колонии в красный (брусничный) цвет.
Назначение
Выделение лактозонегативных патогенных энтеробактерий
(сальмонеллы и шигеллы)

Медицина
Медицина








